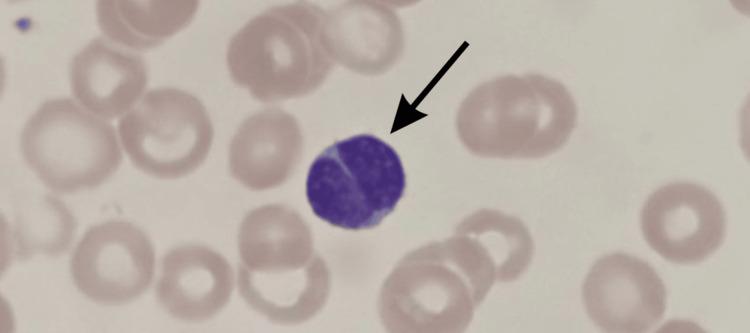
https://cdn.ncbi.nlm.nih.gov/pmc/blobs/fe63/12228118/dbabd88559f8/cureus-0017-00000085395-i01.jpg

一名6个月大婴儿感染百日咳博德特氏菌的非典型表现,伴有核裂淋巴细胞和轻度呼吸窘迫。
Atypical Presentation of Bordetella pertussis in a Six-Month-Old with Cleaved Lymphocytes and Mild Respiratory Distress.
作者信息
Ansari Ali Z, Haque Zayn I, Mokodanski Nicholas A, Patibandla Srihita, Choudhury Sanim, Petroff Dallas J, Hafeez Sahar
机构信息
Department of Pathology and Laboratory Medicine, William Carey University College of Osteopathic Medicine, Hattiesburg, USA.
Department of Pediatrics, Merit Health Wesley, Hattiesburg, USA.
出版信息
Cureus. 2025 Jun 5;17(6):e85395. doi: 10.7759/cureus.85395. eCollection 2025 Jun.
, the causative agent of whooping cough, typically presents in infants with paroxysmal coughing, inspiratory whoop, and post-tussive vomiting; however, atypical presentations are increasingly recognized, particularly in partially or recently immunized individuals. We present the case of a six-month-old previously healthy, fully immunized female infant who was evaluated for a three-day history of low-grade fever, feeding difficulties, increased irritability, and mild respiratory symptoms, in the absence of the characteristic pertussis cough or respiratory distress. Physical examination was largely unremarkable, with no signs of cyanosis, retractions, or abnormal lung sounds. Laboratory testing revealed leukocytosis with marked lymphocytosis, while a peripheral blood smear showed the unexpected presence of cleaved lymphocytes, a finding typically associated with viral infections or lymphoproliferative disorders rather than with pertussis. Despite the non-classical clinical and hematologic features, . was confirmed by polymerase chain reaction (PCR) testing of a nasopharyngeal swab. The patient was treated with azithromycin and supportive care, resulting in clinical improvement and resolution of hematologic abnormalities. This case highlights the diagnostic challenges of pertussis in infants presenting without hallmark symptoms and introduces cleaved lymphocytes as a potential, though uncommon, hematologic feature of the infection.
百日咳的病原体,通常在婴儿中表现为阵发性咳嗽、吸气性吼声和咳嗽后呕吐;然而,非典型表现越来越受到认可,尤其是在部分或近期接种过疫苗的个体中。我们报告一例6个月大、此前健康且已完全接种疫苗的女婴病例,该女婴因低热、喂养困难、易激惹增加和轻度呼吸道症状持续3天而接受评估,无典型的百日咳咳嗽或呼吸窘迫症状。体格检查基本无异常,无发绀、三凹征或异常肺部体征。实验室检查显示白细胞增多伴明显淋巴细胞增多,而外周血涂片显示意外出现核裂淋巴细胞,这一发现通常与病毒感染或淋巴增殖性疾病相关,而非百日咳。尽管有非典型的临床和血液学特征,通过鼻咽拭子聚合酶链反应(PCR)检测确诊为百日咳。患者接受阿奇霉素治疗及支持治疗,临床症状改善,血液学异常消失。该病例突出了无典型症状婴儿百日咳的诊断挑战,并介绍了核裂淋巴细胞作为该感染潜在的(尽管不常见)血液学特征。